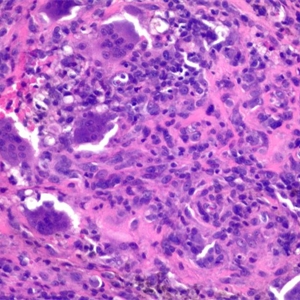

弥漫型腱鞘巨细胞瘤
Gant Cell Tumor of Tendonsheath,Diffuse Type
同义词(或曾用名): 色素性绒毛结节性滑膜炎、色素性绒毛结节性腱鞘滑膜炎
发病部位: 膝部、臀、踝、肘、肩部,少数病例发生于颞下颌区和骶髂。发生于关节外者主要位于膝、大腿和足,其他少见部位包括手指、腕、腹股沟、肘和趾
诊断要点:
多发于青年人,发生于关节内者,以膝关节、髋关节、踝关节、肘肘关节和肩关节等大关节为主,关节外者主要位于膝、大腿和足;
低倍镜下可见杂乱的绒毛结构,弥漫性生长,并浸润周围软组织;
常见裂隙样、假腺样或假腺泡状结构;
细胞密度不一,细胞致密区与疏松区交替分布;
细胞成分复杂,可见单核细胞、破骨细胞、泡沫样组织细胞;
单核细胞有两种,一种为体积较小的组织细胞样细胞,核呈卵圆形或肾形,常见核沟,胞质呈淡嗜伊红色,另一种细胞体积较大,呈圆形或多边形,胞质透亮或深嗜伊红色,染色质空泡状,核仁较明显,周边常见含铁血素,常以第一种细胞为主;
破骨样巨细胞相对较少,少数病例不见巨细胞;
泡沫样组织细胞多少不一,散在或灶状分布;
核分裂像多少不一,部分病例核分裂活跃;
间质常见淋巴细胞浸润。

免疫组织化学染色:
单核细胞 CD68. HAM56. Mac387. FXIIIa 阳性,50%的病例可不同程度表达 Desmin,少数病例表达 HHF35,破骨样多核巨细胞 CD68 和 CD45 常阳性。
分子标记:
CSF1(1p13)易位
鉴别诊断:
含铁血黄素沉积性滑膜炎:与血友病和关节内出血有关,无单核细胞和巨细胞结节状增生,含铁血黄素主要沉积于滑膜的被覆细胞之上。
预后:
局部侵袭性,可见复发,罕见转移。
治疗:
肿瘤切除干净,术后可辅以放疗
病例报道:
Intern Med. 2013;52(10):1149-50. Epub 2013 May 15. Pigmented villonodular synovitis of the ankle.
Lin WT1, Cheng SC, Wu CD, Chiang SS, Hong CY, Chao CM.
参考文献:
Hum Pathol. 2003 Jan;34(1):65-73. Cell characterization of mononuclear and giant cells constituting pigmented villonodular synovitis.
Yoshida W1, Uzuki M, Kurose A, Yoshida M, Nishida J, Shimamura T, Sawai T.
Proc Natl Acad Sci U S A. 2006 Jan 17;103(3):690-5. Epub 2006 Jan 6. A landscape effect in tenosynovial giant-cell tumor from activation of CSF1 expression by a translocation in a minority of tumor cells.
West RB1, Rubin BP, Miller MA, Subramanian S, Kaygusuz G, Montgomery K, Zhu S, Marinelli RJ, De Luca A, Downs-Kelly E, Goldblum JR, Corless CL, Brown PO, Gilks CB, Nielsen TO, Huntsman D, van de Rijn M.
← 非典型纤维组织细胞瘤 局限型腱鞘巨细胞瘤 →
